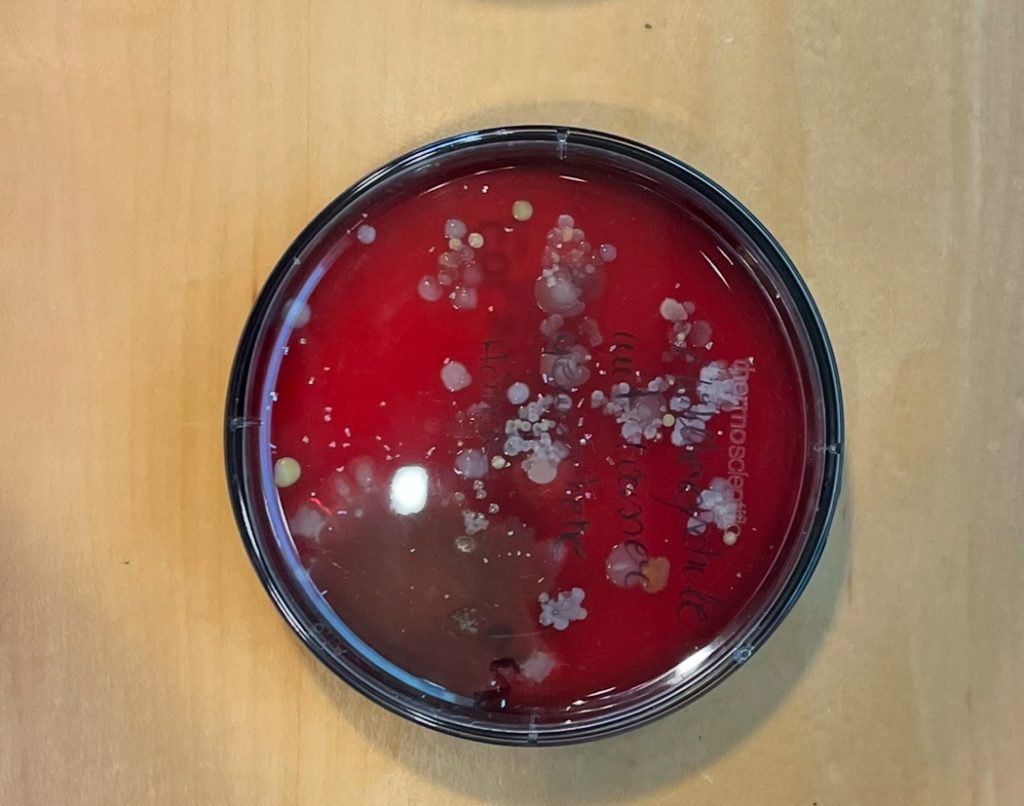

Am 03.03.2026 hat die Klasse 3e an der ersten Kinder-Uni am Uniklinikum zum Thema „Keime und Bakterien“ teilgenommen. Wir konnten forschen wie echte Wissenschaftlerinnen und Wissenschaftler und haben viele spannende Einblicke in die Medizin und Forschung erhalten.
Es war ein sehr interessanter und toller Ausflug!
Herzlichen Dank an Prof. Dr. Christoph und sein Team!